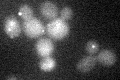
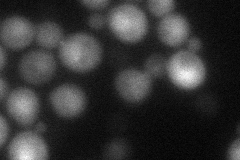
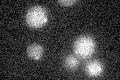

View description
GTP-binding protein of the ras superfamily involved in termination of M-phase; controls actomyosin and septin dynamics during cytokinesis
Localization:
Intensity:
Fold change:
Significance:
-
C’ GFP library in SD
punctate17.97 -
N' NOP1pr-GFP in SD

cytosol,punctate36.7579 -
N' TEF2pr-mCherry in SD
cytosol,nucleus35.9684 -
N' NATIVEpr-GFP in SD

punctate29.1858 -
N' TEF2pr-VC and Cyto-VN in SD

below threshold31.3569 -
C’ GFP library in SD+DTT

punctate14.730.81No -
C’ GFP library in SD+H2O2

punctate18.531.03No -
C’ GFP library in Starvation Media
punctate17.240.95No -
C’ GFP library on the background of Pup2-DaMP

punctate -
C’ GFP library on the background of CCT mutant

punctate18.03061.00309No
